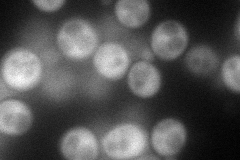
YPL030W
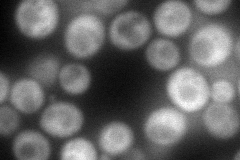
YPL030W
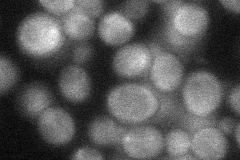
YPL030W
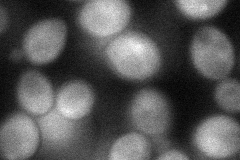
YPL030W
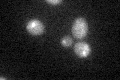
YPL030W
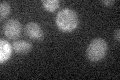
YPL030W

View description
tRNA(Ser) Um(44) 2'-O-methyltransferase; involved in maintaining levels of the tRNA-Ser species tS(CGA) and tS(UGA); conserved among metazoans and fungi but there does not appear to be a homolog in plants; TRM44 is a non-essential gene
Localization:
Intensity:
Fold change:
Significance:
-
C’ GFP library in SD

below threshold15.56 -
N' NOP1pr-GFP in SD
cytosol79.5003 -
N' TEF2pr-mCherry in SD
cytosol111.743 -
N' NATIVEpr-GFP in SD
cytosol36.2524 -
N' TEF2pr-VC and Cyto-VN in SD
cytosol54.353 -
C’ GFP library in SD+DTT
cytosol15.380.98No -
C’ GFP library in SD+H2O2

cytosol14.920.95No -
C’ GFP library in Starvation Media
cytosol15.611No -
C’ GFP library on the background of Pup2-DaMP

below threshold -
C’ GFP library on the background of CCT mutant

below threshold18.07331.16087No
